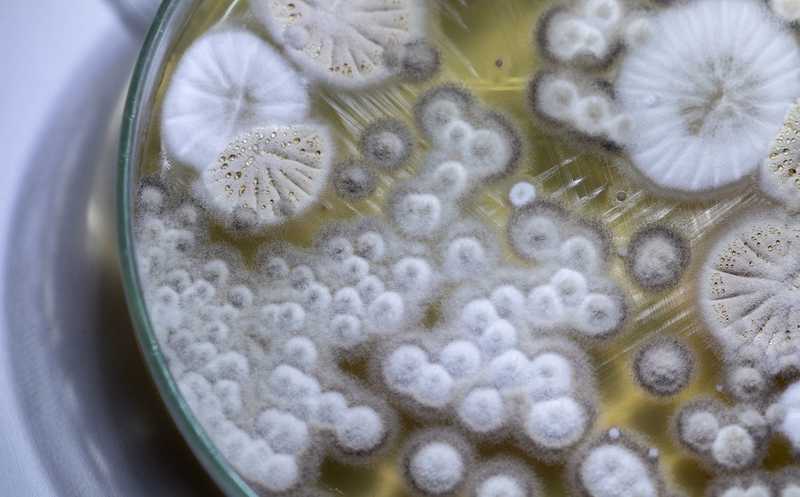

Составлен атлас микобиомов раковых опухолей
Исследователи из Израиля и США проанализировали грибковый состав более 17 000 образцов опухолей и здоровых тканей. Они установили его связь с типом рака, стадией, выживаемостью, иммунным ответом и другими параметрами. Авторы также создали первый атлас раковых микобиомов.
Грибы и другие микроорганизмы могут инфицировать людей с ослабленным иммунитетом, в том числе больных раком. Грибы обнаружены в некоторых типах опухолей, однако их локализация и роль в канцерогенезе плохо изучены. Кроме того, недавно в опухолевых тканях были обнаружены сообщества бактерий и вирусов, которые были метаболически активны, вызывали иммунный ответ и были специфичны для разных типов рака. Все это привело ученых к мысли исследовать роль грибов в развитии онкологических заболеваний и ответить на вопрос, можно ли говорить о таком понятии, как «раковый микобиом».
Сначала ученые убедились, что в опухолях присутствует ДНК грибов. Для этого они исследовали две группы образцов, которые раньше также изучали на наличие бактерий. К первой группе (Weizmann, WIS) относились образцы из восьми типов тканей, как здоровых, так и раковых. В этой группе проводили ампликонное секвенирование, то есть секвенирование фрагмента генома. Во второй группе анализировали данные полногеномного секвенирования и секвенирования РНК из масштабной базы данных — Атласа ракового генома (The Cancer Genome Atlas, TCGA).
В обоих группах была обнаружена ДНК грибов. В группе WIS грибковая нагрузка в опухолях была выше, чем в здоровых тканях, и различалась для разных типов опухолей. Так, например, самая высокая нагрузка была найдена для рака кости и молочной железы. Анализ TCGA также показал присутствие грибов в раковой ткани, но в опухолевом микробиоме преобладали бактерии. При сопоставлении данных обоих групп было показано, что рода грибов в значительной степени пересекались.
Следующим шагом было гистологическое исследование опухолей. С помощью четырех различных методов окрашивался каждый из пяти типов опухолей: меланома, опухоль поджелудочной и молочной желез, легких и яичников. До 25% опухолей каждого типа окрашивались либо на β-глюкан, специфичный для клеточной стенки грибов, либо антителами к грибам рода Aspergillus. А 12% образцов рака поджелудочной железы окрашивались методом FISH (флуоресцентная гибридизация in situ) на 28S рРНК грибов.
Интересна и локализация грибов. При раке легких и меланоме грибы обнаруживались преимущественно в макрофагах. При раке поджелудочной и молочной желез, а также яичников — в самих раковых клетках.
Грибы тесно взаимодействуют с бактериями на физическом и биохимическом уровнях. Кроме того, и грибы, и бактерии способны вызывать у человека специфичные иммунные реакции. Основываясь на этом, авторы статьи выдвинули гипотезу о существовании грибково-бактериально-иммунных кластеров. Для проверки своего предположения они соотнесли роды грибов и бактерий, которые перекрывались в группах WIS и TCGA, а также данные о составе иммунных клеток из базы TCGA. Ученые выявили три грибково-бактериальных кластера, названные «микотипами», и шесть подтипов иммунных реакций. И эти группы действительно пересекались. Так, например, два микотипа были связаны с более сильным воспалительным ответом и активацией макрофагов, они имели лучший прогноз. Авторы отмечают, что эти взаимодействия требуют дальнейшего изучения.
Ученые исследовали связи микобиомов с конкретными типами рака и их стадиями с помощью машинного обучения. Для некоторых типов рака, например, рака желудка, прямой кишки и почки, была найдена зависимость состава микобиома со стадией заболевания.
И, наконец, авторы статьи оценили диагностическую и прогностическую значимость изучения ракового микобиома по аналогии с бактериомом. Для этого они сначала на группе WIS проверили связь грибкового состава с клиническими данными пациентов. Были найдены различия в составе грибов Aspergillus у курящих и некурящих пациентов с раком легкого, сосав Cladosporium был ассоциирован с возрастом у пациентов с раком молочной железы, а состав Phaeosphaeriaceae — с выживаемостью при раке яичников. Затем исследователи провели анализ плазмы крови на ДНК грибов. Этот метод, который в новом исследовании был предложен впервые, смог отличить онкологических больных от здоровых людей и показал связь с ответом на иммунотерапию рака при меланоме.
«Открытие, что грибы обычно представлены в опухолях человека, должно побудить нас лучше изучить их потенциальные эффекты и пересмотреть почти все, что мы знаем о раке через призму микробиома», — сказал Равид Страссман, профессор Института Вейцмана и соавтор статьи. А Грегори Сепич-Пур из компании Micronoma Inc., тоже соавтор статьи, отмечает, что их исследование «может предоставить значительные возможности не только в обнаружении рака, но и в других биотехнологических областях, связанных с разработкой лекарств, эволюцией рака, минимальной остаточной болезнью, рецидивами и диагностикой сопутствующих заболеваний».
Источники:
Lian Narunsky-Haziza, et al. Pan-cancer analyses reveal cancer-type-specific fungal ecologies and bacteriome interactions// Cell, published September 29, 2022, DOI: 10.1016/j.cell.2022.09.005
Цитаты по пресс-релизу


 Меню
Меню





 Все темы
Все темы




 0
0











